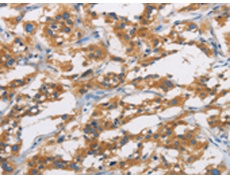
一抗

中文名稱:兔抗SAR1B多克隆抗體
英文名稱: Anti-SAR1B rabbit polyclonal antibody
別 名: ANDD; CMRD; GTBPB; SARA2
抗 原: SAR1B
儲 存: 冷凍(-20℃)
宿 主: Rabbit
相關(guān)類別: 一抗
反應(yīng)種屬: Human, Mouse, Rat
標記物: Unconjugate
克隆類型: rabbit polyclonal
技術(shù)規(guī)格
|
Background: |
The protein encoded by this gene is a small GTPase that acts as a homodimer. The encoded protein is activated by the guanine nucleotide exchange factor PREB and is involved in protein transport from the endoplasmic reticulum to the Golgi. This protein is part of the COPII coat complex. Defects in this gene are a cause of chylomicron retention disease (CMRD), also known as Anderson disease (ANDD). Two transcript variants encoding the same protein have been found for this gene. |
|
Applications: |
ELISA, IHC |
|
Name of antibody: |
SAR1B |
|
Immunogen: |
Fusion protein of human SAR1B |
|
Full name: |
secretion associated, Ras related GTPase 1B |
|
Synonyms: |
ANDD; CMRD; GTBPB; SARA2 |
|
SwissProt: |
Q9Y6B6 |
|
ELISA Recommended dilution: |
1000-2000 |
|
IHC positive control: |
Human thyroid cancer and human liver cancer |
|
IHC Recommend dilution: |
25-100 |

 購物車
購物車 幫助
幫助
 021-54845833/15800441009
021-54845833/15800441009